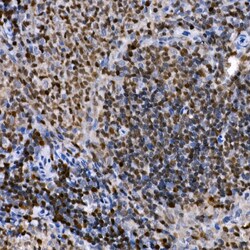

Promotional price valid on web orders only. Your contract pricing may differ. Interested in signing up for a dedicated account number?
Learn More
Learn More
Invitrogen™ PHF11 Polyclonal Antibody


Rabbit Polyclonal Antibody
Supplier: Invitrogen™ PA589229
Description
Immunogen sequence: IAQSAKFSGV KRKRGRKKPL SGNHVQPPET MKCNTFIRQV KEEHGRHTDA TVKVPFLKKC KEAGLLNYLL EEILDKVHSI PEKLMDETTS ESDYEEIGSA LFDCRLFEDT FVNFQAAIEK KIHASQQRWQ QLKEEIELLQ DLKQTLCSFQ ENRDL Positive Samples: SW480; Cellular Location: Nucleus.
PHF11 contains two PHD zinc fingers and probably regulates transcription. Distinctive splice variants were expressed in immune tissues and cells.
Specifications
| PHF11 | |
| Polyclonal | |
| Unconjugated | |
| PHF11 | |
| 4933417L10Rik; APY; atopic; BCAP; BRCA1 C-terminus-associated protein; BRCA1-C terminus associated protein; D14Ertd668e; IgE responsiveness; IgE responsiveness (atopic); IGEL; IGER; IGHER; MGC137849 protein; NYREN34; NY-REN-34; NY-REN-34 antigen; PHD finger protein 11; PHD finger protein 11 family member; PHD finger protein 11A; PHD finger protein 11D; PHD finger protein 11-like; Phf11; Phf11-4; Phf11a; Phf11d; Phf11l; Renal carcinoma antigen NY-REN-34; RP11-185C18.3 | |
| Rabbit | |
| Affinity Chromatography | |
| RUO | |
| 219131, 219132, 361051, 51131 | |
| -20°C, Avoid Freeze/Thaw Cycles | |
| Liquid |
| ELISA, Immunohistochemistry (Paraffin), Western Blot, Immunocytochemistry | |
| 0.28 mg/mL | |
| PBS with 50% glycerol and 0.05% ProClin 300; pH 7.3 | |
| A6H5X4, Q5I0E2, Q8BVM9, Q9UIL8 | |
| PHF11, Phf11a, Phf11d | |
| Recombinant fusion protein containing a sequence corresponding to amino acids 165-319 of human PHF11 (NP_0010355331). | |
| 100 μL | |
| Primary | |
| Human, Mouse, Rat | |
| Antibody | |
| IgG |
Product Content Correction
Your input is important to us. Please complete this form to provide feedback related to the content on this product.
Product Title
Spot an opportunity for improvement?Share a Content Correction